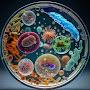

Урок по теме КООРДИНАТНАЯ ПЛОСКОСТЬ
Комментарии:

Кто из 1 школы
Ответить
''O'' (0;0)
Ответить
0;0
Ответить
У начала координат точка (например) О (0;0)
Ответить
Мне будет очень легко я майнкрафтер
Ответить
Смотря по коментам, все с дистанционки. А на вопрос в конце, так я и не нашла ответ.. либо я тугодумная, либо да
Ответить
Большое спасибо ты чудесно обесняешь я все поняла ( хочу стать отличнецей хотя я не хорошиска) прям все объяснить
Ответить
кто 6В??
Ответить
Все понятно урок просто класс лайк кому понравился
Ответить
кто 6 б?
Ответить
(0; 0)
Ответить
У вас билетик просрочен уже 2020 ,а у вас сударь билет на 2016
Ответить
Точка О
Ответить
Да это же идеальный учитель!
Ответить
0(0;0) Вроде так))
Ответить
Кто из 15 шк, невинномысск
Ответить
Как называется приложение ?
Ответить
Кто 6 а из 32 гимназии ?
Ответить
То чувство когда учитель дал какую то левое видео об этой теме просмотрел его ничё не понял, а внизу окозался этот видос и ты пошёл его смотреть чтобы понять тему 😏
Ответить
Спасибо вам большое за урок :D
Это намного лучше, чем смотреть вебинар с заумными бабушками, по часу :\

координаты как в майнкрфте XD
Ответить
Меня одного удевило что он пролайкал все коменты
Ответить
Мне кинули ссылку на другое видео, а я буду смотреть это
Ответить
А что за приложение ?
Ответить
6 Б ВЫ ГДЕ
Ответить
значение 0;0, нет?
Ответить
А кто 6 в
Ответить
А кто 6 б?
Ответить
Ты молодец, продолжай в том же духе! :)
Ответить
Все что я могу сказать так это то что надо подписаться на это учителя и поставить лайк
Ответить
То чуство когда ты на дистантн и те это прислала учительница😆
Ответить
Классно!
Ответить
Билетик в киношку аххааххахаха
Ответить
То чувство когда урок почти закончился а я коменты читаю🙂👍
Ответить
Спасибо,обьяснил!😊
Ответить
круто объясняешь, спасибо
Ответить
ну не понимаю я этого (((
Ответить
Спасибо огромное конечно лайк
Ответить
нечего не-понял
Ответить
А что если кардинаты будут 1;5;7?я только я этим пришёл
Ответить
Спасибо Вам огромное, а то я в школе сижу и не понимаю эту тему спасибо ещё раз🙏🥺
Ответить
Интересный факт: всем это видео прислали учительницы
Ответить
Это очень лёгкая тема, я 5 по контрольной работе получил 😁😁😁😁😁😁
Ответить
вопрос в конце видео я думаю что это координаты (0;0) правильно?
Ответить
Лол я один заметил писаренко
Ответить
Спасибо! Наконец-то я понял эту тему
Ответить
👌 🤡 OK!
🐛💤👚🐛
⛽ 👉
⚡👟
🎸 🌂
👢

большое СПОСИБО не чего не поняла:}
Ответить
Начала координат точка О (0,0).
Ответить

























